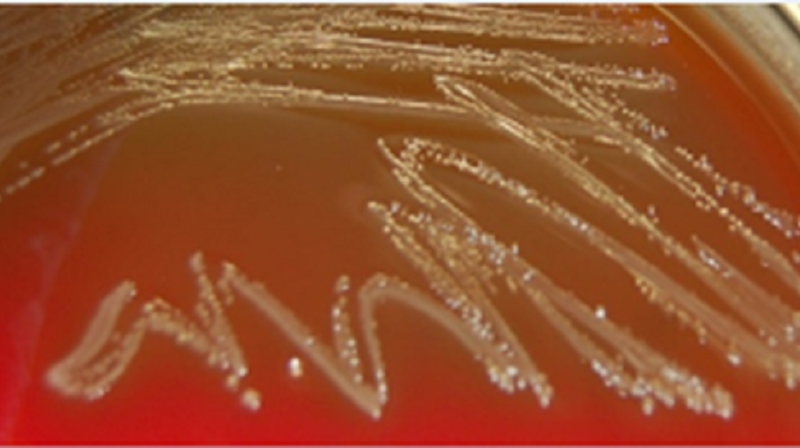

Could bacterial infections cause aggressive prostate cancer?

Grant information
Institution – University of East Anglia
Researcher – Professor Colin Cooper and Professor Daniel Brewer
Grant award - £208,608
Duration of funding – 2015-2018
Status - Complete
Reference – RIA15-ST2-029
This research could lead to prostate cancer being prevented with drugs as simple as antibiotics
The project in a nutshell

- This project aimed to determine whether bacterial infections in the urinary tract cause prostate cancer.
- If the link between bacterial infection and prostate cancer is proven, simple antibiotics may be able to prevent the disease.
- The team also explored if there is any connection between how aggressive a man’s prostate cancer is and the type of bacteria in his urine.
Why did we fund this project?
- The team at University of East Anglia made a chance discovery that men with aggressive or advanced prostate cancer had more bacteria in their urine than men with slow growing or no cancer, meaning the presence of certain bacteria could also tell us how severe a man’s prostate cancer is.
- If bacteria is causing prostate cancer to develop then it could be prevented with treatment as simple as antibiotics.
What did the team do?

- The team built upon their previous work by collecting urine from an additional 300 patients undergoing assessment for prostate cancer at Norfolk and Norwich University Hospital.
- They analysed the urine to determine the species of bacteria present then grouped the different types of bacteria they found to determine which were associated with aggressive disease.
- They then backed up their initial findings by checking the same type of bacteria found in urine was also found in prostate cancer tissue to help them understand how bacterial infection could cause prostate cancer to develop.
What did the team achieve?

- The team found four new species of bacteria from the urine and prostate tissue samples they studied.
- We now have evidence to suggest some of the bacteria might work together to cause prostate cancer.
- New data supports the theory that certain bacteria are linked to more aggressive disease.
How will this benefit men?

- This study may offer men a way of preventing prostate cancer ever developing.
- If the team find which bacteria causes prostate cancer it may then be possible to run a clinical trial to test whether antibiotic treatments against those strains can prevent prostate cancer growth or development.
- The team are also looking to develop their work on bacteria into a urine test to identify men with aggressive prostate cancer, which may inform treatment decisions.
With your help we can beat prostate cancer, together
With your continued support you can help us cure more men with less harm. Take action today and help us work towards a future where men's lives aren't limited by prostate cancer